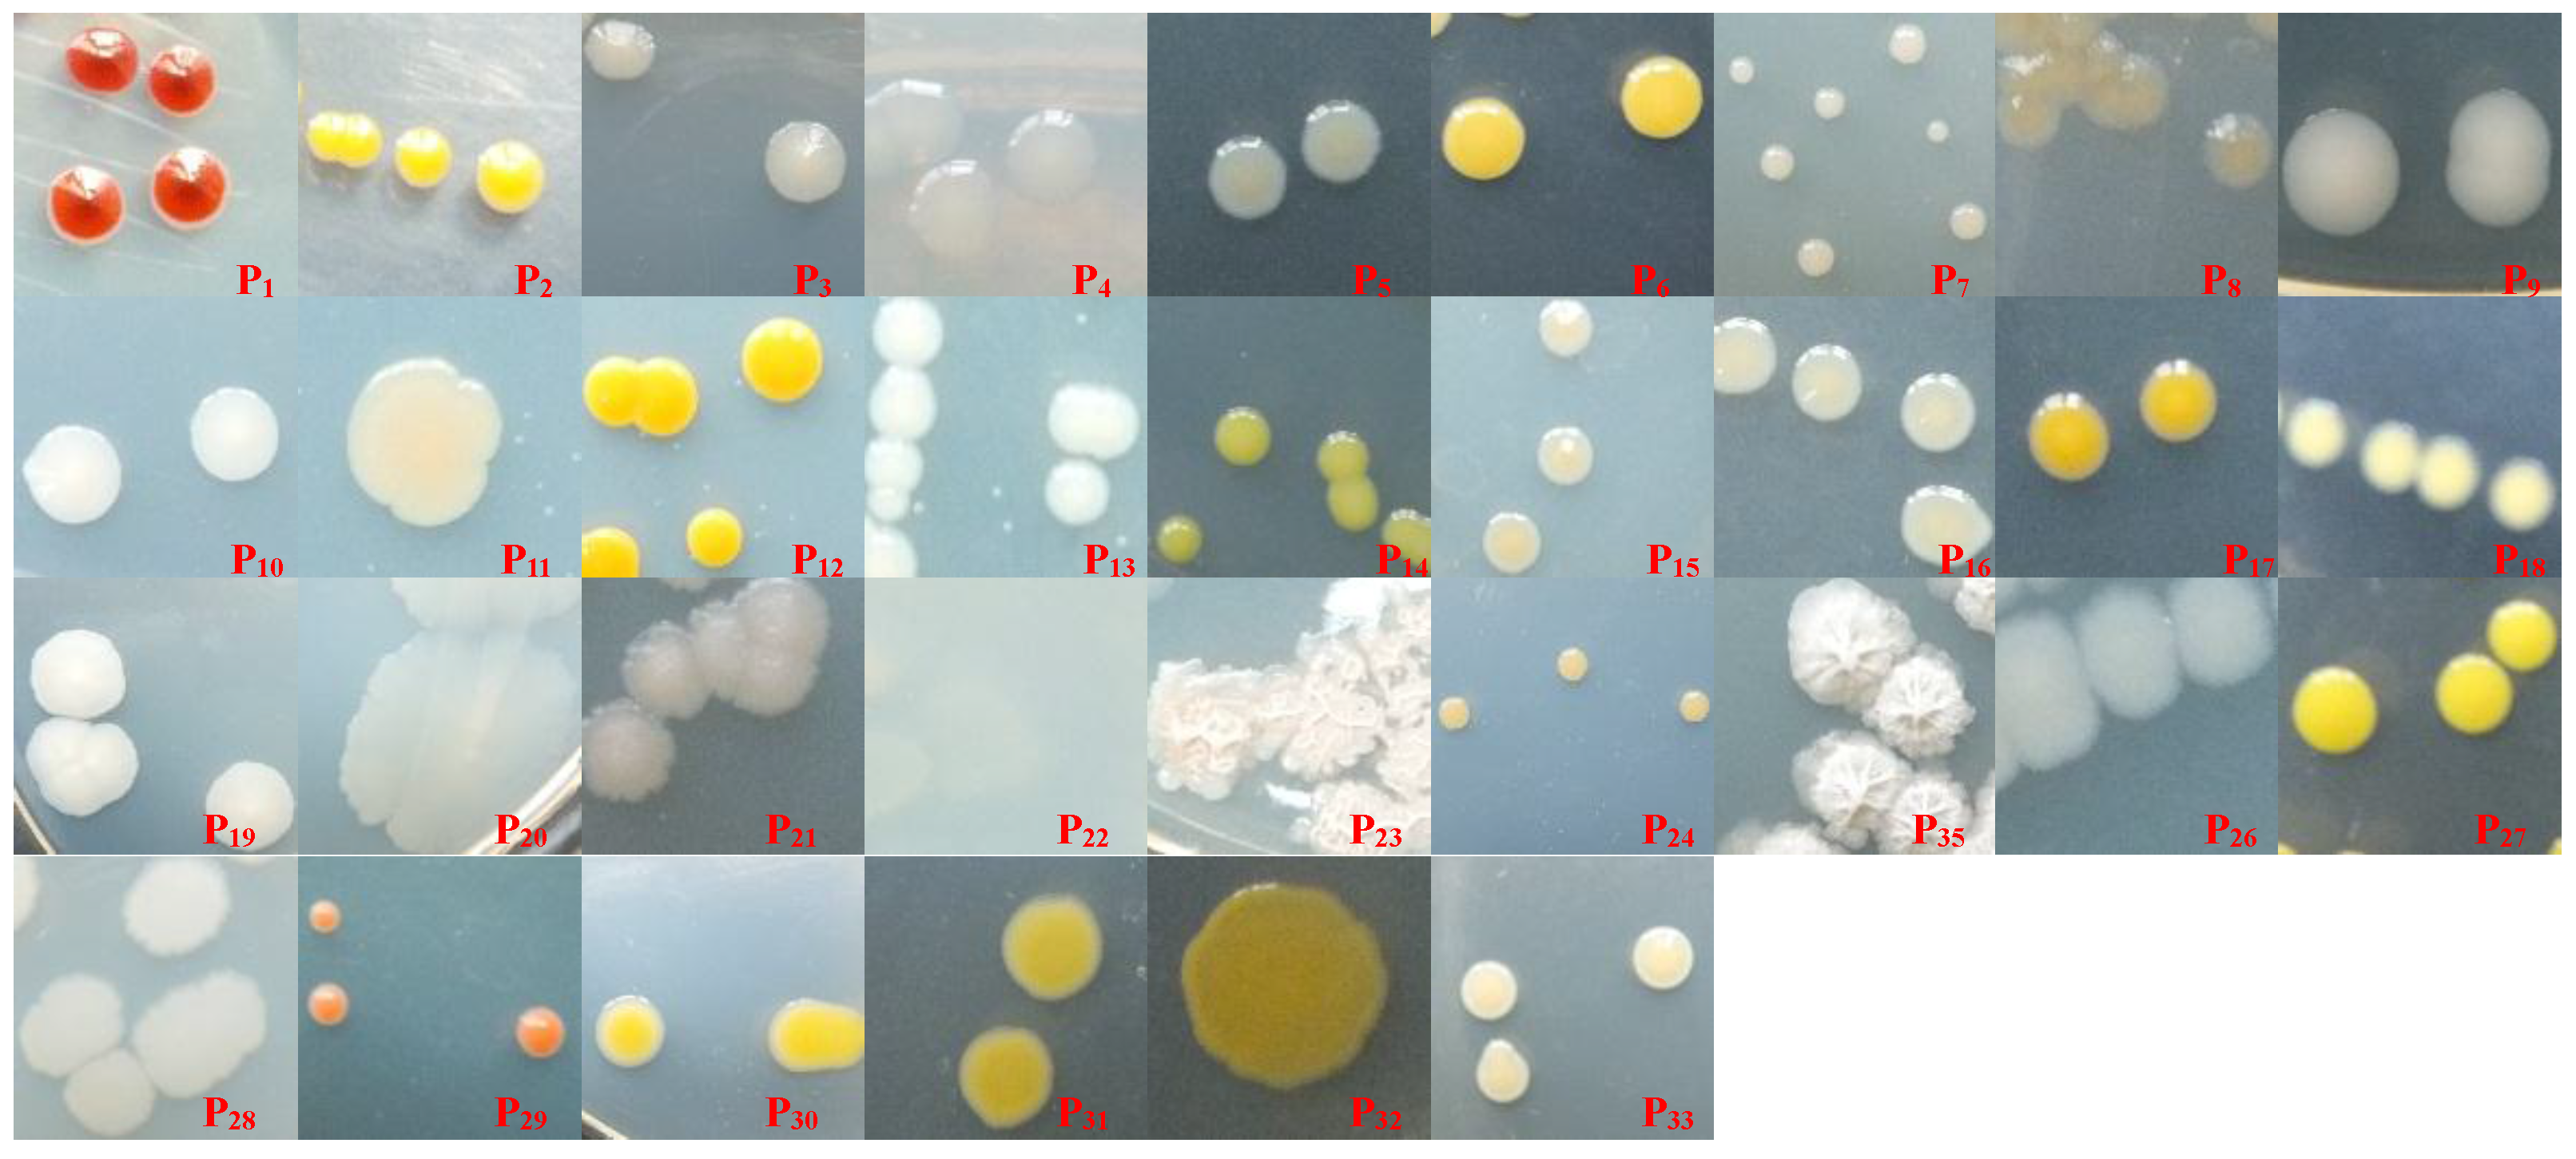
Ijerph 13 01081 g002

Phenanthrene and Pyrene Modify the Composition and Structure of the Cultivable Endophytic Bacterial Community in Ryegrass (Lolium multiflorum Lam)
Abstract
:1. Introduction
2. Materials and Methods
2.1. Experimental Materials
2.2. Exposure of Plants to PAHs
2.3. Isolation and Identification of Endophytic Bacteria
2.4. Degradation of PAHs by Endophytic Bacteria
2.5. Concentrations of PAHs
2.6. Statistical Analyses
3. Results and Discussion
3.1. Numbers of Cultivable Endophytic Bacteria
3.2. Diversity of Cultivable Endophytic Bacteria
3.3. Dominant Endophytic Bacteria and Their Abilities to Degrade PAHs
4. Conclusions
Acknowledgments
Author Contributions
Conflicts of Interest
References
- Juhasz, A.L.; Naidu, R. Bioremediation of high molecular weight polycyclic aromatic hydrocarbons: A review of the microbial degradation of benzo(a)pyrene. Int. Biodeterior. Biodegrad. 2000, 45, 57–88. [Google Scholar] [CrossRef]
- Hu, Y.; Wen, J.Y.; Wang, D.Z.; Du, X.Y.; Li, Y. An interval dynamic multimedia fugacity (IDMF) model for environmental fate of PAHs and their source apportionment in a typical oilfield. China Chem. Ecol. 2013, 29, 476–488. [Google Scholar] [CrossRef]
- Chen, G.S.; White, P.A. The mutagenic hazards of aquatic sediments. Mutat. Res. 2004, 567, 151–225. [Google Scholar] [CrossRef] [PubMed]
- Gan, S.; Lau, E.V.; Ng, H.K. Remediation of soils contaminated with polycyclic aromatic hydrocarbons (PAHs). J. Hazard. Mater. 2009, 172, 532–549. [Google Scholar] [CrossRef] [PubMed]
- Chen, F.; Tan, M.; Ma, J.; Zhang, S.L.; Li, G.; Qu, J.F. Efficient remediation of PAH-metal co-contaminated soil using microbial-plant combination: A greenhouse study. J. Hazard. Mater. 2016, 302, 250–261. [Google Scholar] [CrossRef] [PubMed]
- Child, R.; Miller, C.D.; Liang, Y.; Narasimham, G.; Chatterton, J.; Harrison, P.; Sims, R.C.; Britt, D.; Anderson, A.J. Polycyclic aromatic hydrocarbon-degrading Mycobacterium isolates: Their association with plant roots. Appl. Microbiol. Biotechnol. 2007, 75, 655–663. [Google Scholar] [CrossRef] [PubMed]
- Sun, K.; Liu, L.; Jin, L.; Gao, Y.Z. Utilizing pyrene-degrading endophytic bacteria to reduce the risk of plant pyrene contamination. Plant Soil 2014, 374, 251–262. [Google Scholar] [CrossRef]
- Cruz-Hernández, A.; Tomasini-Campocosio, A.; Pérez-Flores, L.J.; Fernández-Perrino, F.J.; Gutiérrez-Rojas, M. Inoculation of seed-borne fungus in the rhizosphere of Festuca arundinacea promotes hydrocarbon removal and pyrene accumulation in roots. Plant Soil 2013, 362, 261–270. [Google Scholar] [CrossRef]
- Eevers, N.; Hawthorne, J.R.; White, J.C.; Vangronsveld, J.; Weyens, N. Exposure of cucurbita pepo to DDE-contamination alters the endophytic community: A cultivation-dependent vs. a cultivation-independent approach. Environ. Pollut. 2016, 209, 147–154. [Google Scholar] [CrossRef] [PubMed]
- Hung, P.Q.; Annapurna, K. Isolation and characterization of endophytic bacteria in soybean (Glycine sp.). Omonrice 2004, 12, 92–101. [Google Scholar]
- GenBank Database. Available online: http://www.ncbi.nlm.nih.gov/ (accessed on 2 November 2016).
- Sherman, C.; Grishkan, I.; Barness, G.; Steinberger, Y. Fungal community-plant litter decomposition relationships along a climate gradient. Pedosphere 2014, 24, 437–449. [Google Scholar] [CrossRef]
- Abostate, M.A.; Moustafa, Y.M.; Mohamed, N.H. Biodegradation of slop wax by Bacillus species isolated from chronic crude oil contaminated soils. Fuel. Process. Technol. 2011, 92, 2348–2352. [Google Scholar] [CrossRef]
- Jurelevicius, D.; Alvarez, V.M.; Peixoto, R.; Rosado, A.S.; Seldin, L. Bacterial polycyclic aromatic hydrocarbon ring-hydroxylating dioxygenases (PAH-RHD) encoding genes in different soils from King George Bay, Antarctic Peninsula. Appl. Soil Ecol. 2012, 55, 1–9. [Google Scholar] [CrossRef]
- Xia, W.J.; Du, Z.F.; Cui, Q.F.; Dong, H.; Wang, F.Y.; He, P.Q.; Tang, Y.C. Biosurfactant produced by novel Pseudomonas sp. WJ6 with biodegradation of N-alkanes and polycyclic aromatic hydrocarbons. J. Hazard. Mater. 2014, 276, 489–498. [Google Scholar] [CrossRef] [PubMed]
- Benedek, T.; Vajna, B.; Táncsics, A.; Márialigeti, K.; Lányi, S.; Máthé, I. Remarkable impact of PAHs and TPHs on the richness and diversity of bacterial species in surface soils exposed to long-term hydrocarbon pollution. World J. Microbiol. Biotechnol. 2013, 29, 1989–2002. [Google Scholar] [CrossRef] [PubMed]
- MacNaughton, S.J.; Stephen, J.R.; Venosa, A.D.; Davis, G.A.; Chang, Y.; White, D.C. Microbial population changes during bioremediation of an experimental oil spill. Appl. Environ. Microbiol. 1999, 65, 3566–3574. [Google Scholar] [PubMed]
- Andreoni, V.; Cavalca, L.; Rao, M.A.; Nocerino, G.; Bernasconi, S.; Dell’Amico, E.; Colombo, M.; Gianfreda, L. Bacterial communities and enzyme activities of PAHs polluted soils. Chemosphere 2004, 57, 401–412. [Google Scholar] [CrossRef] [PubMed]
- Phillips, L.A.; Germida, J.J.; Farrell, R.E.; Greer, C.W. Hydrocarbon degradation potential and activity of endophytic bacteria associated with prairie plants. Soil Biol. Biochem. 2008, 40, 3054–3064. [Google Scholar] [CrossRef]
- Urbano, M.; Elango, V.; Pardue, J.H. Biogeochemical characterization of MC252 oil: Sand aggregates on a coastal headland beach. Mar. Pollut. Bull. 2013, 77, 183–191. [Google Scholar] [CrossRef] [PubMed]

| Group | CK | T1 | T2 | T3 | T4 | T5 | T6 |
|---|---|---|---|---|---|---|---|
| Phenanthrene (PHE) (μg·L−1) | 0 | 100 | 800 | 0 | 0 | 100 | 800 |
| Pyrene (PYR) (μg·L−1) | 0 | 0 | 0 | 20 | 500 | 20 | 500 |
| Group | Concentration of PAHs in the Roots | Concentration of PAHs in the Shoots | ||
|---|---|---|---|---|
| PHE | PYR | PHE | PYR | |
| CK | 5.10 ± 1.55 c | n.d. | 3.38 ± 0.72 c | n.d. |
| T1 | 56.95 ± 4.98 b | n.d. | 19.33 ± 0.76 bc | n.d. |
| T2 | 346.49 ± 38.18 a | n.d. | 144.68 ± 14.53 a | n.d. |
| T3 | 32.14 ± 4.79 bc | 31.29 ± 3.04 c | 39.55 ± 10.79 b | n.d. |
| T4 | 28.10 ± 6.04 bc | 812.44 ± 316.65 a | 22.35 ± 1.76 bc | 184.72 ± 35.34 a |
| T5 | 58.19 ± 8.55 b | 30.93 ± 4.07 c | 32.19 ± 9.61 b | 4.37 ± 1.65 b |
| T6 | 353.45 ± 27.00 a | 452.35 ± 39.66 b | 152.70 ± 27.54 a | 205.20 ± 101.59 a |
| Class | Genus | Bacterial Strain | Isolation from the Roots | Isolation from the Shoots | ||||||||||||
|---|---|---|---|---|---|---|---|---|---|---|---|---|---|---|---|---|
| CK | T1 | T2 | T3 | T4 | T5 | T6 | CK | T1 | T2 | T3 | T4 | T5 | T6 | |||
| γ-Proteobacteria | Enterobacter | P3 | + | |||||||||||||
| P4 | + | |||||||||||||||
| P10 | + | |||||||||||||||
| P14 | + | |||||||||||||||
| P18 | + | + | ||||||||||||||
| P20 | + | + | + | + | ||||||||||||
| P26 | + | |||||||||||||||
| Stenotrophomonas | P5 | + | ||||||||||||||
| P8 | + | |||||||||||||||
| P15 | + | |||||||||||||||
| P16 | + | + | ||||||||||||||
| P33 | + | + | + | + | + | + | + | + | ||||||||
| Pantoea | P30 | + | + | |||||||||||||
| P31 | + | + | + | + | + | + | + | + | ||||||||
| P32 | + | |||||||||||||||
| Pseudomonas | P21 | + | + | + | + | + | ||||||||||
| P24 | + | + | ||||||||||||||
| Serratia | P1 | + | + | + | + | + | + | + | ||||||||
| P2 | + | + | + | + | + | |||||||||||
| Klebsiella | P9 | + | + | + | + | + | + | + | ||||||||
| Fusobacteria | Bacillus | P19 | + | + | + | + | + | + | + | |||||||
| P23 | + | + | + | |||||||||||||
| P25 | + | + | + | + | + | + | ||||||||||
| P28 | + | + | ||||||||||||||
| Sphingobacteria | Sphingobacterium | P6 | + | + | ||||||||||||
| P17 | + | + | ||||||||||||||
| Pedobacter | P29 | + | + | + | + | + | ||||||||||
| α-Proteobacteria | Rhizobium | P7 | + | + | + | + | + | + | + | + | + | + | ||||
| Agrobacterium | P13 | + | ||||||||||||||
| β-Proteobacteria | Delftia | P22 | + | |||||||||||||
| Bacilli | Solibacillus | P11 | + | + | + | + | ||||||||||
| Flavobacteria | Chryseobacterium | P12 | + | + | + | + | + | + | ||||||||
| Actinobacteria | Arthrobacter | P27 | + | |||||||||||||
| Sums of bacterial strains | 11 | 8 | 10 | 6 | 10 | 6 | 6 | 6 | 9 | 7 | 12 | 8 | 6 | 6 | ||
| Sums of genera | 7 | 7 | 7 | 6 | 8 | 6 | 6 | 5 | 7 | 6 | 9 | 6 | 6 | 6 | ||
| Sums of classes | 4 | 4 | 3 | 2 | 4 | 4 | 2 | 4 | 3 | 5 | 8 | 3 | 4 | 6 | ||
| Plant Tissue | Group | H | J | Dominant | Number | Degradation Rate (%) | ||
|---|---|---|---|---|---|---|---|---|
| Bacterial Strain | Genus | Log CFU·g−1 (pi) | PHE | PYR | ||||
| Roots | CK | 1.447 | 0.603 | P4 | Enterobacter sp. | 6.95 (45.9%) | 73.4 ± 24.4 | 68.5 ± 8.8 |
| P3 | Enterobacter sp. | 6.78 (30.7%) | 71.6 ± 31.8 | 25.2 ± 4.2 | ||||
| T1 | 1.898 | 0.913 | P33 | Stenotrophomonas sp. | 6.02 (23.5%) | 99.0 ± 0.1 | 17.2 ± 5.9 | |
| P7 | Rhizobium sp. | 5.97 (21.2%) | 12.8 ± 5.4 | 8.7 ± 1.9 | ||||
| T2 | 1.469 | 0.638 | P30 | Pantoea sp. | 7.56 (41.0%) | 99.9 ± 0.1 | n.d. | |
| P33 | Stenotrophomonas sp. | 7.47 (33.7%) | 99.0 ± 0.1 | 17.2 ± 5.9 | ||||
| T3 | 1.370 | 0.764 | P1 | Serratia sp. | 7.35 (32.0%) | 97.3 ± 1.5 | 49.2 ± 8.2 | |
| P25 | Bacillus sp. | 7.33 (31.0%) | 99.8 ± 0.2 | 16.9 ± 9.5 | ||||
| T4 | 1.039 | 0.451 | P1 | Serratia sp. | 7.92 (57.1%) | 97.3 ± 1.5 | 49.2 ± 8.2 | |
| P9 | Klebsiella sp. | 7.64 (30.5%) | 67.8 ± 10.5 | 9.2 ± 11.6 | ||||
| T5 | 1.578 | 0.881 | P25 | Bacillus sp. | 6.24 (35.3%) | 99.8 ± 0.2 | 16.9 ± 9.5 | |
| P9 | Klebsiella sp. | 6.17 (29.5%) | 67.8 ± 10.5 | 9.2 ± 11.6 | ||||
| T6 | 0.610 | 0.340 | P16 | Stenotrophomonas sp. | 7.97 (84.6%) | 68.2 ± 11.5 | n.d. | |
| P30 | Pantoea sp. | 6.94 (7.9%) | 99.9 ± 0.1 | n.d. | ||||
| Shoots | CK | 1.534 | 0.856 | P12 | Chryseobacterium sp. | 4.92 (38.6%) | 92.5 ± 6.4 | n.d. |
| P13 | Agrobacterium | 4.65 (20.6%) | 28.6 ± 2.9 | 46.2 ± 24.5 | ||||
| T1 | 2.015 | 0.917 | P33 | Stenotrophomonas sp. | 5.53 (25.8%) | 99.0 ± 0.1 | 17.2 ± 5.9 | |
| P19 | Bacillus sp. | 5.34 (16.7%) | 35.3 ± 29.0 | 22.8 ± 15.4 | ||||
| T2 | 1.768 | 0.908 | P7 | Rhizobium sp. | 5.51 (29.9%) | 12.8 ± 5.4 | 8.7 ± 1.9 | |
| P33 | Stenotrophomonas sp. | 5.44 (25.4%) | 99.0 ± 0.1 | 17.2 ± 5.9 | ||||
| T3 | 2.116 | 0.852 | P20 | Enterobacter sp. | 5.11 (21.6%) | 14.6 ± 18.9 | n.d. | |
| P19 | Bacillus sp. | 5.10 (21.3%) | 35.3 ± 29.0 | 22.8 ± 15.4 | ||||
| T4 | 2.033 | 0.978 | P33 | Stenotrophomonas sp. | 4.36 (19.1%) | 99.0 ± 0.1 | 17.2 ± 5.9 | |
| P25 | Bacillus sp. | 4.33 (17.7%) | 99.8 ± 0.2 | 16.9 ± 9.5 | ||||
| T5 | 1.412 | 0.788 | P7 | Rhizobium sp. | 4.86 (41.5%) | 12.8 ± 5.4 | 8.7 ± 1.9 | |
| P9 | Klebsiella sp. | 4.72 (29.5%) | 67.8 ± 10.5 | 9.2 ± 11.6 | ||||
| T6 | 1.159 | 0.647 | P19 | Rhizobium sp. | 6.00 (66.4%) | 35.3 ± 29.0 | 22.8 ± 15.4 | |
| P7 | Bacillus sp. | 5.16 (9.4%) | 12.8 ± 5.4 | 8.7 ± 1.9 | ||||
© 2016 by the authors; licensee MDPI, Basel, Switzerland. This article is an open access article distributed under the terms and conditions of the Creative Commons Attribution (CC-BY) license (http://creativecommons.org/licenses/by/4.0/).
Share and Cite
Zhu, X.; Jin, L.; Sun, K.; Li, S.; Li, X.; Ling, W. Phenanthrene and Pyrene Modify the Composition and Structure of the Cultivable Endophytic Bacterial Community in Ryegrass (Lolium multiflorum Lam). Int. J. Environ. Res. Public Health 2016, 13, 1081. https://doi.org/10.3390/ijerph13111081
Zhu X, Jin L, Sun K, Li S, Li X, Ling W. Phenanthrene and Pyrene Modify the Composition and Structure of the Cultivable Endophytic Bacterial Community in Ryegrass (Lolium multiflorum Lam). International Journal of Environmental Research and Public Health. 2016; 13(11):1081. https://doi.org/10.3390/ijerph13111081
Chicago/Turabian StyleZhu, Xuezhu, Li Jin, Kai Sun, Shuang Li, Xuelin Li, and Wanting Ling. 2016. "Phenanthrene and Pyrene Modify the Composition and Structure of the Cultivable Endophytic Bacterial Community in Ryegrass (Lolium multiflorum Lam)" International Journal of Environmental Research and Public Health 13, no. 11: 1081. https://doi.org/10.3390/ijerph13111081
APA StyleZhu, X., Jin, L., Sun, K., Li, S., Li, X., & Ling, W. (2016). Phenanthrene and Pyrene Modify the Composition and Structure of the Cultivable Endophytic Bacterial Community in Ryegrass (Lolium multiflorum Lam). International Journal of Environmental Research and Public Health, 13(11), 1081. https://doi.org/10.3390/ijerph13111081
